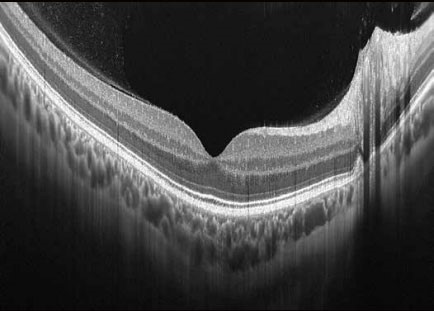

АКЦІЇ! ПЕРЕГЛЯНУТИ ПОВНИЙ ПЕРЕЛІК ДОСТУПНИХ ПРОПОЗИЦІЙ МОЖНА ТУТ
Оптико-когерентний томограф XEPHILIO OCT-A1

Під замовлення
Стан: новий
Виробник: Canon Inc. (Японія)
Гарантія: 12 місяців
Сервісний супровід: гарантійний та післягарантійний
Умови оплати
- безготівковий розрахунок
Доставка
- згідно умов договору постачання
Ви можете покладатися щодня на виняткову простоту у користуванні та видатну продуктивність Xephilio OCT-A1. Безліч автоматизованих функцій оптимізують та спрощують ваші дослідження, у той час як висока швидкість сканування гарантує скорочення часу дослідження, підвищує ефективність роботи та зручність для пацієнтів.

Завдяки визнаній оптиці Canon, Xephilio OCT-A1 пропонує чудову якість зображення. З цифровою розподільчою здатністю до 1.6 мкм система дозволяє чудово диференціювати структури та окремі шари сітківки.
Висока швидкість сканування 70,000 A-сканів/сек забезпечує скорочення часу дослідження, зазвичай приблизно до двох секунд, та призводить до зменшення артефактів руху й підвищення комфорту пацієнта.
Зображення високої якості
Xephilio OCT-A пропонує відмінну оптичну розподільну здатність. Усередненням безлічі сканів (до 200)досягається прекрасна якість зображення з дивовижною деталізацією.

Точне сканування, видатна простота використання
Вбудований скануючий лазерний офтальмоскоп значно сприяє якості сканування та простоті використання. Забезпечення відстеження сітківки у режимі реального часу дозволяє точно контролювати обстеження.

Швидке та чітке відстеження
Скануючий лазерний офтальмоскоп точно слідкує за обстеженням та автоматично підлаштовує позицію сканування під те саме положення, що було під час попереднього сканування. Для надійного порівняння програмне забезпечення автоматично обирає однакові параметри сканування.
АВТОМАТИЧНЕ НАЛАШТУВАННЯ ВИСОКОЇ ЯКОСТІ ЗОБРАЖЕННЯ
Часом, мимовільні рухи очей під час дослідження неминучі. З вбудованим скануючим лазерним офтальмоскопом з технологією відстеження сітківки у реальному часі система дозволяє встановити ту саму позицію сканування автоматично. В результаті трекінг сітківки Xephilio OCT-значно знижує артефакти руху та таким чином забезпечується постійна висока якість зображення.

Висока чіткість, збільшена глибина, широке поле зору
За допомогою Xephilio OCT-A1 ви можете усереднити до 200 сканувань, щоб досягти розподільчої здатності зображення, що дозволяє детально бачити як структуру шарів сітківки, так і пошарову структуру скловидного тіла. Для оптимальної візуалізації система пропонує спеціальні режими сканування для скловидного та судинного зображення, а також особливо широку ширину сканування до 13 мм

Надійне розпізнавання 10 шарів
Xephilio OCT-A1 компанії Canon може автоматично виявити та розрізнити 10 шарів сітківки, включаючи мембрану Бруха (BM) - завдяки чудовій якості зображення та розподільчій здатності.
НЕЙМОВІРНА ДЕТАЛІЗАЦІЯ
Дослідження на Xephilio OCT-A1 робити дуже просто, повний спектр інтелектуальних функцій дозволяє повністю автоматизувати процес обстеження. Функція автоматичного повторного сканування втручається, якщо пацієнт робить небажані рухи очей і автоматично компенсує будь-які артефакти.
Автоматичне відстеження на передній ділянці ока
Після позиціонування приблизно на центр зіниці система автоматично виявляє є та підтримує точний центр, навіть коли пацієнт рухає оком або моргає.

Автоматична оптимізація зображення
Вбудовані функції автоматичного фокусування та К-затвору автоматично визначають найвищу якість сигналу для найкращих можливих результатів експертизи.
Відстеження сітківки в режимі реального часу
Виявляючи та компенсуючи рухи в зображеннях кард за кадром, вплив від невеликих мимовільних рухів знижується під час фіксації, а артефакти руху значно зменшуються.
ШВИДКІ, ТОЧНІ ДОСЛІДЖЕННЯ - ВИСОКИЙ КОМФОРТ ПАЦІЄНТА
Xephilio OCT-A1 пропонує десять фіксованих і вільно програмованих пресетів для досліджень, що дозволяє поєднувати кілька режимів сканування в одному дослідженні. Використання пресетів може допомогти вам покращити робочий процес та послідовність досліджень, в той же час, підвищити комфорт пацієнта.
УНІВЕРСАЛЬНІ МОЖЛИВОСТІ У ЗВІТУВАННІ, ШИРОКІ НОРМАТИВНІ БАЗИ ДАНИХ
Xephilio OCT-A1 надає вам повний спектр інструментів звітності, включаючи відповідні нормативні бази даних. Завдяки широким можливостям формату DICOM та базам даних EMR, результати досліджень з апаратів Canon можна зберігати та обмінюватися й аналізувати їх за потребою у вашій щоденній практиці.

Макула
Система забезпечує детальний аналіз товщини сітківки за допомогою порівнянь з нормативними базами даних, сітками ETDRS, різними таблицями та 3D-візуалізаціями.

Глаукома
Раннє виявлення глаукоми є запорукою уповільнення її прогресування. Xephilio OCT-A1 підтримує вимірювання NFL + GCL + IPL та GCL + IPL з широким набором графічних зображень для повного аналізу.
СПІЛЬНИЙ ЗВІТ
Використовуючи спільну з ретинальною камерою базу даних, зображення очного дна можна легко інтегрувати з оцінюванням ОКТ. Зображення з ретинальної камери та оптико-когерентного томографа за потребою можна відображати разом, картографувати та накладати.

Оптичний диск
Xephilio OCT-A1 дозволяє всебічно проаналізувати всі параметри оптичного диска, та порівняти їх за допомогою широкої нормативної бази даних.

Звіт про прогрес
Результатом аналізу є порівняння п’яти обстежень, що зроблені у різні проміжки часу на тому ж самому оку в однакових режимі сканування та розміру області сканування.
АНАЛІЗ ПЕРЕДНЬОГО СЕГМЕНТУ
Завдяки додатковому адаптеру переднього сегмента ASA-1, Xephilio OCT-A1 надає вам можливість проаналізувати та задокументувати передній сегмент без необхідності додаткового дослідження. Включений пакет вимірювань дозволяє швидко та легко оцінити стандартні параметри.
Аналіз товщини рогівки на Xephilio OCT-A1 представлений у вигляді карт товщини рогівки та товщини епітелію, включаючи корнеальні сітки, а також числової таблиці.


Програма для аналізу переднього сегмента дозволяє виміряти відстань між двома точками, довільні кути, а також значення AOD (відстань відкриття кута) та TISA іридо-трабекулярний простір.
Загальні параметри
| Швидкість сканування | 70 000 А-сканів/сек |
| Продольна розподільна здатність | Цифрова/Оптична 1,6/3 мкм |
| Поперечна розподільна здатність | 20 мкм |
| Довжина хвилі | 855 ± 5 нм, вихід на рогівку ˂ 2.67 мВт (скануючий промінь контролюється системою безпеки лазеру) |
| Мінімальний діаметр зіниці | 3 мм |
| Робоча відстань | 35 мм |
| Діапазон регулювання фокуса | від -18 D до + 15 D |
| Попередній перегляд очного дна | Лазерний скануючий офтальмоскоп SLO SLO розмір (горизонталь х вертикаль) 13 мм х 10 мм ОКТ ширина 3 – 13 мм ОКТ глибина 2 мм |
| Розмір сканування | 3 мм – 10 мм |
| Світло внутрішньої фіксації | 1 мм х 1 мм або 6 мм х 6 мм |
| Світло зовнішньої фіксації | лампа EL-1 (опція) |
| Розміри (Ш х Г х В) | 387 х 499 х 474 мм |
| Вага | 29 кг |
Параметри сканування ОКТ
| Режим сканування сітківки | Режими дослідження скловидного тіла та хоріоідеї: Нормальний / інверсний |
| Позиціонування зображення (позиціонування світла фіксації) | Макула/Диск/Задній відрізок Macula 3D 1024 A-сканів (горизонтальне) х 128 B-сканів площа сканування 10 мм х10 мм Glaucoma 3D 1024 A-сканів (вертикальне) х 128 B-сканів площа сканування 10 мм х10 мм Disk 3D 512 А-сканів (горизонтальне) х 256 В-сканів площа сканування 6 мм х 6 мм Custom 3D 1024 A-сканів (горизонтальне/вертикальне) х 128 B-сканів площа сканування 3 х 3 мм, 6 х 6 мм, 10 х 10 мм Multi Cross Горизонтальне:1024 A-сканів (H) від 3 до 13 мм Вертикальне: 1024 A-сканів (V) від 3 до 10 мм Усереднення: 1 - 50 Cross Горизонтальне:1024 A-сканів (H) від 3 до 13 мм Вертикальне: 1024 A-сканів (V) від 3 до 10 мм Усереднення: 1 - 200 Radial 1024 A-сканів (3 мм/6 мм/10 мм) 12 напрямків (інтервал 15°) Усереднення: 1 - 50 |
| ОСТА | ОКТ ангіографія (опція) |
| Режим сканування переднього відрізка | Напрямок К-воріт: нормальний Позиціонування зображення: центр скануючого лазерного офтальмоскопа Anterior 3D 9 мм горизонтальний Anterior Cross 3 мм / 9 мм горизонтальний Усереднення: 1 – 200 Anterior Radial 9 мм 12 напрямків (інтервал 15°) |
Режими сканування - запрограмовані пресети
Хвороби макули: Macula 3D/Multi Cross
Глаукома: Glaucoma 3D/Disk 3D/Cross
Хоріоїдея: Macula 3D/Multi Cross
Загальні дослідження: Glaucoma/Disk 3D/Cross
Передній сегмент: Anterior Cross/Radial/3D
Можливість запрограмувати додатково до 5 режимів сканування користувачем.
ВІЗУАЛІЗАЦІЯ МІКРОСУДИН СІТКІВКИ ЗА ДОПОМОГОЮ ОКТ АНГІОГРАФІЇ
ОКТ-ангіографія - це досконала технологія, яка виявляє рух еритроцитів у судинній сітці сітківки та дозволяє детально візуалізувати крихітні судини.
Неінвазивне дослідження з результатом через секунди.
ОКТ ангіографія не потребує введення флюоресцеїну або розширення зіниці, а обстеження займає лише кілька секунд. Відстеження сітківки у режимі реального часу за допомогою скануючого лазерного офтальмоскопа мінімізує артефакти. Найточніша обробка зображень з видаленням артефактів 3D проекцій забезпечує чудову якість зображення.

Вільне обирання шарів
За допомогою ОКТ ангіографії навіть найменші судини можна представити у 2D та 3D режимах.
Програмне забезпечення ОКТ Ангіо від Canon дозволяє вільно обирати шари для створення бажаного зображення.
Шари можна визначати на основі автоматичної сегментації або на власний вибір.
ОКТ ангіографія (опція)
Програмне забезпечення Angio Expert Lite (ліцензія OCTA) |
|
| Програмне забезпечення OCTA2 |
|
| Програмне забезпечення ОСТА Analysis |
|
Програмне забезпечення Angio Expert HD | включає в себе ОСТА, OCTA2, OCTA Analysis |

